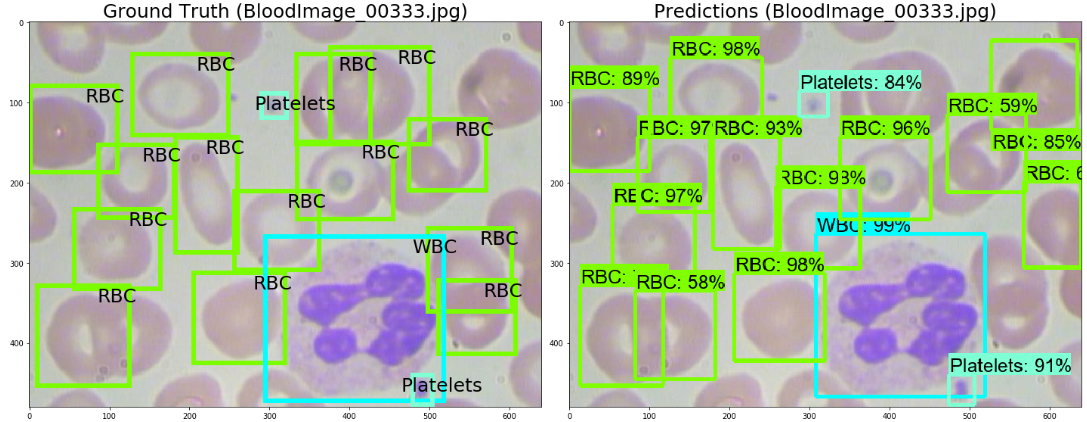

A smaller image size 32 x 32 pixel has a better result but as the image. Image Recognition - Tensorflow.

Setup Object Detection Using Tensorflow Gpu Complete Guide On Windows By Manoj Sisodia Medium
Active 2 years 5 months ago.

. Not long after that we could read about the GAN network that can create photorealistic images from simple sketches. The number of pixels kernel should add. Active 1 year 2 months ago.
Printing tensor flow version printtf__version__. Question 1-Why use a Data Flow graph to solve Mathematical expressions. Firstly Use unzip datazip to unzipped it and then images belonging to different categories are placed in.
There can be multiple classes that the image can be labeled as or just one. Modelsave my_modelh5 In this tutorial you discovered how you can train CNN image classification mode using TensorFlow Keras High-Level API. In comparison to recognition algorithms a detection algorithm does not only predict class labels but detects locations of objects as well.
The code that accompanies this article can be downloaded here. Install TensorFlow dependencies. Image_tensor detection_graphget_tensor_by_nameimage_tensor0 Output tensors are the detection boxes scores and classes Each box represents a part of the image where a particular object was detected.
Jan 17 2018 4 min read. How to save and load a checkpoint. Image Recognition using TensorFlow.
With relatively same images it will be easy to implement this logic for security purposes. Viewed 171 times 0 I am using a Convolutional Neural Network CNN for image detection of 30 different kinds of fruits. To build Yolo were going to need Tensorflow deep learning NumPy numerical computation and Pillow image processing libraries.
The dataset I have currently consists of train and test folders each of them having 30 sub directories for the 30 different classes. The format of dataset. Image recognition refers to the task of inputting an image into a neural network and having it output some kind of label for that image.
Ask Question Asked 2 years 8 months ago. But to train a neural network I have to have at least 2 classes so I must have the. The image_batch is a tensor of the shape 32 180 180 3.
Pip install -q h5py pyyaml. One of the most popular image classification STL-10 only achieves an accuracy of 7433 with 96 x 96 pixel images. Also read The Difference Data Analysis and Data Science.
Label Class 0. On CPU with Inception-v3In seconds SAGAR SHARMA. Image recognition model collection.
And what I want to do is to train a neural network so it would recognize whether its me on the given image or not. TensorFlow includes a special feature of image recognition and these images are stored in a specific folder. How to use the Tensorboard callback of Keras.
The label_batch is a tensor of the shape 32 these are corresponding labels to the 32 images. Question 4-TensorFlow can replace Numpy. The labels are an array of integers ranging from 0 to 9.
It is the fastest and the simplest way to do image recognition on your laptop or computer without any GPU because it is just an API and your CPU is good enough for this. Ask Question Asked 1 year 2 months ago. Also I am going to use seaborns color.
Im wondering how far has our mankind progressed in image recognition with computers. The number of pixels kernel should be moved. These correspond to the class of clothing the image represents.
Viewed 188 times 1 So say I have a data set with photos of myself. Collection of classic image recognition models egResNet Alexnet VGG19 inception_V4 in Tensorflow. A couple of days ago news about AI that could detect shoplifters even before they commit the crime surfaced on the web.
If there is a single class the term recognition is often applied whereas a multi-class recognition task. Ive tried to do a random Google search about image processing. This is a batch of 32 images of shape 180x180x3 the last dimension refers to color channels RGB.
The folder structure of image recognition code implementation is. I know Im a little late with this specific API because it came with the early edition of. The label that the network outputs will correspond to a pre-defined class.
Image Classification With TensorFlowjs. You can call numpy on the image_batch and labels_batch tensors to convert them to a. Train folder has in total 671.
Question 3-Why TensorFlow is considered fast and suitable for Deep Learning. Single class image recognition with TensorFlow and Keras. TensorFlow Image Recognition Python API Tutorial.

Tensorflow Object Detection Realtime Object Detection With Tensorflow Tensorflow Python Edureka Youtube

Nothing Is Being Detected In Tensorflow Object Detection Api Stack Overflow

Supercharge Image Classification With Transfer Learning By Raghav Bali Towards Data Science

Creating Your Own Object Detector With The Tensorflow Object Detection Api

Tensorflow Object Detection Learn Python

Ocr Handwriting Recognition With Opencv Keras And Tensorflow Pyimagesearch
Detection And Classification Of Blood Cells With Deep Learning Part 2 Training And Evaluation By Steven Towards Data Science

Image Classification Using Tensorflow On Custom Dataset Debuggercafe

Ros Tutorials Tensorflow Image Recognition In 5 Steps With Ros Development Studio The Construct

Object Detection Vs Object Recognition Vs Image Segmentation Geeksforgeeks

Image Classification Using Tensorflow Pretrained Models Debuggercafe

Object Detection Bounding Box Regression With Keras Tensorflow And Deep Learning Pyimagesearch

Raspberry Pi Tensorflow Lite Image Classification And Object Detection Easy Guide

Real Time Object Detection With Tensorflow Detection Model By Naveen Manwani Towards Data Science

Live Object Detection With The Tensorflow Object Detection Api

Using Tensorflow Object Detection To Do Pixel Wise Classification By Priya Dwivedi Towards Data Science

Tensorflow Object Detection Learn Python

Object Detection Tutorial In Tensorflow Perform Real Time Object Detection By Sayantini Deb Edureka Medium

0 komentar:
Posting Komentar